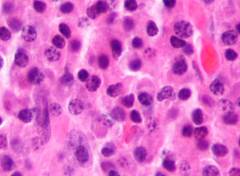

Что такое плазмоциты?
Плазмоциты или плазматические клетки – специализированные клетки, вырабатывающие антитела, ключевые для иммунной системы. Они являются разновидностью лейкоцитов, формирующихся из В-лимфоцитов. Плазмоциты находятся в красном костном мозге, лимфатических узлах, кишечнике и небных миндалинах.
У здоровых людей плазмоциты составляют около 5% клеток в костном мозге. Превышение 10% может указывать на заболевание.
Функции плазмоцитов заключаются в производстве антител-иммуноглобулинов, обеспечивающих защиту организма в крови, лимфе и слюне. Плазмоциты действуют как одноклеточные железы, вырабатывающие сотни иммуноглобулинов каждую секунду.
Как формируются плазмоциты? Процесс включает несколько этапов:
- В-лимфоциты, предшественники плазмоцов, развиваются из стволовых клеток в печени и костном мозге, начиная с эмбрионального периода.
- В-лимфоциты попадают в лимфатические узлы, селезенку и лимфоидную ткань кишечника для созревания.
- В этом процессе В-лимфоциты взаимодействуют с антигенами (частями бактерий или вирусов), при этом участвуют другие иммунные клетки, такие как моноциты и макрофаги. В результате В-лимфоциты начинают вырабатывать специфичные иммуноглобулины, например, против вируса гриппа.
- После активации В-лимфоциты выделяют антитела и превращаются в иммунобласты.
- Иммунобласты активно делятся, образуя множество идентичных клеток, способных производить одинаковые антитела.
- В финальной стадии клонированные клетки становятся плазмоцитами, вырабатывающими иммуноглобулины и защищающими организм от чуждых антигенов, таких как вирусы и бактерии.
Миеломная болезнь, или плазмоцитома, представляет собой злокачественное заболевание, возникающее из плазматических клеток. Врачи отмечают, что точные причины развития миеломы до конца не изучены, однако факторы риска включают возраст, генетическую предрасположенность и воздействие определенных химических веществ. Симптомы болезни могут варьироваться, но чаще всего пациенты жалуются на боли в костях, анемию, повышенную утомляемость и частые инфекции.
Диагностика миеломной болезни включает анализы крови и мочи, а также визуализирующие исследования, такие как рентген или МРТ. Лечение обычно комбинирует химиотерапию, радиотерапию и, в некоторых случаях, трансплантацию стволовых клеток. Прогноз зависит от стадии заболевания и общего состояния пациента, но современные методы терапии значительно улучшили выживаемость и качество жизни больных. Врачи подчеркивают важность ранней диагностики и индивидуального подхода к каждому пациенту для достижения наилучших результатов.

Что такое миеломная болезнь?
На одной из фаз созревания В-лимфоцитов может произойти сбой, в результате которого вместо плазмоцита формируется миеломная клетка с злокачественными свойствами. Все миеломные клетки происходят от одной мутировавшей клетки, которая многократно клонировалась. Скопление этих клеток называется плазмоцитомой. Опухоли могут возникать как в костях, так и в мышцах, и бывают одиночными (солитарными) или множественными.
Злокачественная клетка формируется в костном мозге и прорастает в костную ткань, где миеломные клетки активно делятся. Обычно они не попадают в кровь, но выделяют большое количество патологического иммуноглобулина, известного как парапротеин, который не участвует в иммунной защите и откладывается в тканях.
При попадании в костную ткань миеломные клетки взаимодействуют с окружающей средой. Они активируют остеокласты, разрушающие хрящи и костную ткань, образуя пустоты.
Миеломные клетки выделяют цитокины, выполняющие несколько функций:
- Стимулируют рост миеломных клеток. Чем больше миеломных клеток, тем быстрее появляются новые очаги болезни.
- Угнетают иммунитет, что приводит к частым бактериальным инфекциям.
- Активизируют остеокласты, вызывая разрушение костей и болевые ощущения.
- Стимулируют рост фибробластов, увеличивая вязкость плазмы крови и вызывая синяки и кровотечения.
- Вызывают рост гепатоцитов в печени, что нарушает образование протромбина и фибриногена, снижая свертываемость крови.
- Нарушают белковый обмен (особенно при миеломе Бенса-Джонса), что может привести к поражению почек.
Болезнь развивается медленно. С момента появления первых миеломных клеток до появления клинической картины может пройти 20-30 лет. Однако после появления первых симптомов, без лечения, болезнь может привести к летальному исходу в течение 2 лет.
Причины миеломной болезни не установлены. Врачи не пришли к единому мнению о том, что вызывает мутацию В-лимфоцита в миеломную клетку.
Кто в группе риска развития миеломной болезни?
- Мужчины. Миеломная болезнь чаще развивается у мужчин, особенно с возрастом. Женщины болеют реже.
- Возраст 50-70 лет. Люди младше 40 лет составляют лишь 1% больных, так как с возрастом иммунная система менее эффективно распознает раковые клетки.
- Генетическая предрасположенность. У 15% пациентов есть родственники с этой формой лейкоза, что связано с мутацией гена, отвечающего за созревание В-лимфоцитов.
- Ожирение нарушает обмен веществ и снижает иммунитет, создавая условия для появления злокачественных клеток.
- Воздействие радиоактивного облучения (например, ликвидаторы аварии на ЧАЭС, пациенты, прошедшие лучевую терапию) и длительное воздействие токсинов (асбест, мышьяк, никотин) увеличивают вероятность мутации в процессе формирования плазмоцита.
При плазмоцитоме страдают кости, почки и иммунная система. Симптомы зависят от стадии развития опухоли. У 10% пациентов клетки не вырабатывают парапротеины, и болезнь протекает бессимптомно.
На ранних стадиях, когда злокачественных клеток немного, болезнь может не проявляться. Однако с увеличением их количества они начинают заменять нормальные клетки костного мозга, и в кровь поступает много парапротеинов, негативно влияющих на организм.
Симптомы:
- Боли в костях. Под воздействием миеломных клеток в костях образуются полости, вызывая ноющую боль, усиливающуюся при повреждении надкостницы.
- Боли в сердце, суставах и мышцах связаны с отложением патологических белков, нарушающих функционирование органов.
- Патологические переломы. Из-за разрушения костной ткани развиваются остеопороз и хрупкость костей, что приводит к переломам даже при незначительных нагрузках.
- Снижение иммунитета. Костный мозг вырабатывает недостаточно лейкоцитов, что угнетает защитные силы организма и приводит к частым инфекциям.
- Гиперкальциемия. Из разрушенной костной ткани кальций попадает в кровь, вызывая запоры, боли в животе и эмоциональные расстройства.
- Нарушение функции почек – миеломная нефропатия возникает из-за отложения кальция в почечных протоках и нарушения белкового обмена.
- Анемия, при которой снижается выработка эритроцитов, что приводит к кислородному голоданию клеток, проявляющемуся быстрой утомляемостью и головной болью.
- Нарушения свертываемости крови. Повышенная вязкость плазмы может привести к образованию тромбов и спонтанным кровотечениям.
- Сбор анамнеза. Врач анализирует наличие болей в костях, утомляемости, слабости и других симптомов. Учитываются хронические заболевания и вредные привычки. На основе результатов исследований ставится диагноз и назначается лечение.
- Осмотр. Выявляются внешние признаки миеломной болезни, такие как опухоли, кровоизлияния и бледность кожи.
- Общий анализ крови. Лабораторное исследование, позволяющее оценить состояние системы кроветворения. О миеломной болезни свидетельствуют повышенная СОЭ и сниженное количество эритроцитов.
- Биохимический анализ крови позволяет оценить работу органов. Миеломную болезнь подтверждают увеличение общего белка, снижение альбумина и повышение уровня кальция.
- Миелограмма (трепанобиопсия) – исследование клеток костного мозга. Результаты показывают большое количество плазматических клеток и угнетение нормального кроветворения.
- Лабораторные маркеры миеломной болезни определяются в крови и моче, где могут быть обнаружены парапротеины.
- Общий анализ мочи позволяет выявить изменения, свидетельствующие о поражении почек.
- Рентгенография костей помогает выявить участки поражения костей и подтвердить диагноз.
- Спиральная компьютерная томография (СКТ) позволяет оценить распространенность миеломной болезни.
Для лечения миеломной болезни применяются различные методы:
- Химиотерапия – лечение токсичными препаратами, воздействующими на миеломные клетки.
- Трансплантация костного мозга или стволовых клеток.
- Лучевая терапия – используется для лечения одиночных плазмоцитом.
- Хирургическое вмешательство – удаление поврежденной кости при одиночных плазмоцитомах.
Химиотерапия является основным методом лечения как одиночных, так и множественных плазмоцитом.
Монохимиотерапия – лечение с использованием одного препарата.
| Препарат | Механизм действия | Способ применения |
| Мелфалан | Эффективность 50%. Углеродные соединения встраиваются в ДНК миеломных клеток, останавливая их размножение. | По 0,15–0,2 мг на килограмм массы тела в течение 4 дней. Интервал между курсами – 4 недели. |
| Циклофосфамид | Эффективность около 50%. Встраивается в ДНК злокачественной клетки, нарушая процесс деления. | Внутрь по 50–200 мг на протяжении 2-3 недель. Внутримышечно по 200–400 мг. |
| Леналидомид | Эффективен у 60% пациентов, повышает выживаемость до 42 месяцев. | Капсулу 25 мг принимают ежедневно после еды. Курс лечения – 3 недели, затем 7 дней перерыва. |
Химиотерапевтические препараты назначает врач, имеющий опыт в использовании цитостатиков. Необходим постоянный контроль за состоянием пациента.
Полихимиотерапия – лечение с использованием комплекса противоопухолевых средств. Наиболее эффективными схемами являются VAD и VBMCP.
Схема VAD
| Препараты | Механизм действия | Способ применения |
| Винкристин | Блокирует белок, необходимый для деления миеломных клеток. | По 0,4 мг/день 1-4 дня. |
| Адриамицин | Подавляет рост клеток, образуя свободные радикалы. | Вводят внутривенно по 9 мг/м² поверхности тела в день. |
| Дексаметазон | Применяется для профилактики побочных эффектов. | Принимают по 40 мг/день в определенные дни. |
Схема VBMCP
| Препараты | Механизм действия | Способ применения |
| Кармустин | Угнетает обменные процессы в клетках. | Вводится внутривенно в первый день лечения. |
| Винкристин | Блокирует митотическое деление клеток. | Вводится внутривенно в первый день лечения. |
| Циклофосфамид | Оказывает токсическое действие на злокачественные клетки. | Назначается индивидуально. |
| Мелфалан | Останавливает синтез белка, необходимого для размножения миеломных клеток. | Применяется внутрь. |
| Преднизолон | Применяется для уменьшения побочных эффектов. | Принимается внутрь. |
После достижения ремиссии назначают интерферон для поддержания организма. Химиотерапия может угнетать кроветворение, поэтому может потребоваться трансфузия.
Эффективность полихимиотерапии: у 41% пациентов наблюдается полное исчезновение симптомов, у 50% – значительное улучшение. Однако у многих пациентов может возникнуть рецидив.
- Обезболивание проводится по трехступенчатой системе: I ступень – нестероидные противовоспалительные препараты для слабой боли. II ступень – слабые опиоиды для усиления обезболивания. III ступень – опиоиды сильного действия для выраженной боли.
-
Процедуры для обезболивания:
- Магнитотурботрон – лечение магнитным полем, уменьшающим боль и активирующим иммунитет.
- Электросон – воздействие на мозг токами, снижающее чувствительность к боли.
- Нарушение обмена кальция требует употребления достаточного количества жидкости и применения препаратов, таких как ибандронат натрия и кальцитонин.
- Лечение почечной недостаточности включает препараты, поддерживающие функцию почек и выводящие токсины.
Выздоровление при миеломной болезни встречается редко. Возможности лечения включают пересадку костного мозга, удаление поврежденной кости и трансплантацию стволовых клеток. Длительная ремиссия возможна при раннем выявлении болезни и отсутствии тяжелых сопутствующих заболеваний. Химиотерапия низкими дозами может обеспечить 2-летнюю выживаемость у 90% пациентов. Без лечения продолжительность жизни не превышает 2 лет.
| Характеристика | Подробности | Примечания |
|---|---|---|
| Причины миеломной болезни | Генетические мутации, приводящие к неконтролируемому размножению плазматических клеток. Воздействие ионизирующего излучения, некоторые химические вещества. Вирусная инфекция (гипотеза). Возраст (чаще после 65 лет). | Точная причина неизвестна, часто сочетание факторов. |
| Симптомы миеломной болезни | Боль в костях, переломы, анемия (усталость, бледность), потеря веса, почечная недостаточность, гиперкальциемия (тошнота, рвота, запор), инфекции (частые и тяжелые), нейропатия (онемение, покалывание), амилоидоз (повреждение органов). | Симптомы могут быть неспецифическими и проявляться постепенно. |
| Диагностика миеломной болезни | Анализ крови (выявление М-белка, снижение количества здоровых клеток крови), анализ мочи (выявление Бэнс-Джонса белка), миелограмма (исследование костного мозга), рентгенография костей (выявление поражений), биопсия костного мозга (подтверждение диагноза). | Необходим комплексный подход к диагностике. |
| Лечение миеломной болезни | Химиотерапия, таргетная терапия, иммуномодулирующая терапия, высокодозная химиотерапия с аутологичной трансплантацией стволовых клеток, лучевая терапия (для локальных поражений), бисфосфонаты (для предотвращения переломов и гиперкальциемии). | Выбор метода лечения зависит от стадии заболевания и общего состояния пациента. |
| Прогноз миеломной болезни | Зависит от стадии заболевания, возраста пациента, наличия осложнений. Современные методы лечения значительно улучшили прогноз. Возможно длительное выживание и поддержание хорошего качества жизни. | Регулярное наблюдение у онколога необходимо. |
Миеломная болезнь, или плазмоцитома, вызывает множество обсуждений среди пациентов и врачей. Люди часто отмечают, что основными симптомами являются боли в костях, усталость и частые инфекции. Многие пациенты делятся своими переживаниями о том, как болезнь влияет на качество жизни и эмоциональное состояние. Причины миеломы до конца не изучены, но генетические факторы и воздействие определенных химических веществ могут играть роль. Диагностика включает анализы крови, МРТ и биопсию костного мозга, что вызывает у людей страх и неопределенность. Лечение, как правило, комплексное и может включать химиотерапию, иммунотерапию и трансплантацию стволовых клеток. Прогноз зависит от стадии заболевания и индивидуальных особенностей пациента, и многие отмечают, что ранняя диагностика и адекватное лечение значительно улучшают шансы на долгосрочную ремиссию.

Причины миеломной болезни
Причины миеломной болезни остаются неясными. В медицинском сообществе нет единого мнения о причинах мутации В-лимфоцитов в миеломные клетки.
Кто в группе риска развития миеломной болезни?
- Мужчины. У мужчин миеломная болезнь чаще развивается на фоне снижения уровня тестостерона с возрастом. У женщин заболевание встречается реже.
- Возраст от 50 до 70 лет. Лица младше 40 лет составляют всего 1% заболевших. С возрастом иммунная система менее эффективно распознает и уничтожает раковые клетки.
- Генетическая предрасположенность. У 15% пациентов есть родственники с этой формой лейкоза, что может быть связано с мутацией гена, отвечающего за созревание В-лимфоцитов.
- Ожирение. Избыточный вес нарушает обмен веществ и ослабляет иммунную систему, создавая условия для возникновения злокачественных клеток.
- Воздействие радиоактивного облучения (например, ликвидаторы аварии на Чернобыльской АЭС, пациенты, проходившие лучевую терапию) и длительное воздействие токсических веществ (асбест, мышьяк, никотин). Эти факторы увеличивают вероятность мутаций в процессе формирования плазмоцитов, что может привести к их превращению в миеломные клетки и образованию опухоли.
Симптомы миеломной болезни
При плазмоцитоме поражаются кости, почки и иммунная система. Симптомы миеломной болезни зависят от стадии заболевания. У 10% пациентов клетки не производят парапротеины, и болезнь протекает бессимптомно.
На начальных этапах, когда злокачественных клеток немного, болезнь может не проявляться. Со временем их количество увеличивается, заменяя здоровые клетки костного мозга. В кровь попадает много парапротеинов, негативно влияющих на организм.
Симптомы:
- Боли в костях. Миеломные клетки формируют полости в костной ткани, раздражая болевые рецепторы и вызывая ноющую боль, усиливающуюся при повреждении надкостницы.
- Боли в сердце, суставах и мышечных сухожилиях возникают из-за отложения патологических белков, нарушающих функционирование органов и раздражающих рецепторы.
- Патологические переломы. Злокачественные клетки образуют пустоты в костях, что приводит к остеопорозу. Кости становятся хрупкими и могут ломаться даже при незначительных нагрузках, чаще всего это переломы бедренных костей, ребер и позвонков.
- Снижение иммунитета. Нарушение функции костного мозга приводит к недостаточной выработке лейкоцитов, ослабляя защитные механизмы организма. Уровень нормальных иммуноглобулинов снижается, что вызывает частые бактериальные инфекции, такие как отит, ангина и бронхит, которые плохо поддаются лечению.
- Гиперкальциемия. Из разрушенной костной ткани в кровь попадает много кальция, вызывая запоры, боли в животе, тошноту, учащенное мочеиспускание, эмоциональные расстройства, слабость и заторможенность.
- Нарушение функции почек – миеломная нефропатия возникает из-за отложения кальция в почечных протоках в виде камней и нарушений белкового обмена. Парапротеины откладываются в канальцах нефронов, что приводит к сморщиванию почки (нефросклерозу) и нарушению оттока мочи, вызывая застой жидкости. При миеломной нефропатии отеки отсутствуют, артериальное давление остается нормальным.
- Анемия, в основном нормохромная – цветовой показатель (соотношение гемоглобина к количеству эритроцитов) остается в пределах 0,8 — 1,05. Повреждение костного мозга снижает выработку эритроцитов, что приводит к уменьшению концентрации гемоглобина и кислородному голоданию клеток. Это проявляется быстрой утомляемостью и снижением концентрации внимания. При физической нагрузке могут возникать одышка, сердцебиение, головная боль и бледность кожи.
- Нарушения свертываемости крови. Повышенная вязкость плазмы приводит к спонтанному склеиванию эритроцитов, что может способствовать образованию тромбов. Снижение уровня тромбоцитов (тромбоцитопения) вызывает спонтанные кровотечения, такие как носовые и десенные. При повреждении мелких капилляров кровь может выходить под кожу, образуя синяки и кровоподтеки.

Диагностика миеломной болезни
-
Сбор анамнеза. Врач выясняет, когда начались боли в костях, онемение, усталость и слабость, а также наличие кровотечений и синяков. Учитываются хронические заболевания и вредные привычки пациента. На основе лабораторных и инструментальных исследований устанавливается диагноз, форма и стадия миеломной болезни, а также назначается лечение.
-
Осмотр. Во время осмотра выявляются признаки миеломной болезни:
- опухоли в области костей и мышц.
- кровоизлияния из-за нарушений свертываемости крови.
- бледность кожи – признак анемии.
- учащенный пульс – реакция сердца на недостаток гемоглобина.
-
Общий анализ крови. Это исследование оценивает состояние системы кроветворения и наличие заболеваний. Забор крови производится утром натощак. Для анализа берется 1 мл крови из пальца или вены. Лаборант изучает каплю крови под микроскопом и использует автоматические анализаторы.
Показатели, указывающие на миеломную болезнь:
- повышение СОЭ – свыше 60-70 мм/час
- снижение эритроцитов – у мужчин менее 4 10^12 клеток/л, у женщин менее 3,7 10^12 клеток/л
- снижение ретикулоцитов – менее 0,88%
- снижение тромбоцитов – менее 180 10^9 клеток/л
- снижение лейкоцитов – менее 4 10^9 клеток/л
- снижение нейтрофилов – менее 1500 в 1 мкл
- повышение моноцитов – свыше 0,7 10^9
- снижение гемоглобина – менее 100 г/л
- наличие 1-2 плазматических клеток в крови.
Угнетение функции кроветворения в костном мозге приводит к уменьшению клеток крови. Общее количество белка увеличивается за счет парапротеинов. Высокий уровень СОЭ указывает на злокачественную патологию.
-
Биохимический анализ крови позволяет оценить работу органов по содержанию веществ в крови. Забор крови осуществляется утром натощак, до приема лекарств и других исследований. Кровь берется из вены. В лаборатории добавляют реагенты, которые реагируют с определяемыми веществами. Миеломную болезнь подтверждают:
- увеличение общего белка – свыше 90-100 г/л
- снижение альбумина – менее 38 г/л
- повышение кальция – свыше 2,75 ммоль/литр
- повышение мочевой кислоты – у мужчин свыше 416,5 мкмоль/л, у женщин свыше 339,2 мкмоль/л
- повышение креатинина – у мужчин свыше 115 мкмоль/л, у женщин свыше 97 мкмоль/л
- повышение мочевины – более 6,4 ммоль/л
Эти отклонения указывают на увеличение белка в крови за счет парапротеинов, выделяемых миеломными клетками. Высокие уровни мочевой кислоты и креатинина свидетельствуют о поражении почек.
-
Миелограмма (трепанобиопсия) – исследование клеточного состава костного мозга. Пункция выполняется с помощью трепана или иглы И. А. Кассирского. Извлекается образец клеток костного мозга, который затем изучается под микроскопом.
Результаты при миеломной болезни могут включать:
- значительное количество плазматических клеток – свыше 12%
- наличие клеток с большим количеством цитоплазмы и характерным рисунком в ядерном хроматине
- угнетение нормального кроветворения
- большое количество незрелых нетипичных клеток
Эти изменения указывают на нарушение работы костного мозга, где функциональные клетки заменены злокачественными плазматическими клетками.
-
Лабораторные маркеры миеломной болезни
Для анализа берется кровь из вены. В некоторых случаях используется моча. В сыворотке крови выявляются парапротеины, выделяемые миеломными клетками. У здоровых людей эти иммуноглобулины отсутствуют.
Парапротеины определяются с помощью иммуноэлектрофореза. Кровь помещается в гель, после чего проводится электрофорез. Антигены перемещаются и располагаются на стекле в виде характерных дуг.
В зависимости от типа миеломы могут быть выявлены:
- парапротеин класса IgG
- парапротеин класса IgA
- парапротеин класса IgD
- парапротеин класса IgE
- бета-2 микроглобулин
Этот анализ считается наиболее чувствительным и точным для диагностики миеломной болезни.
-
Общий анализ мочи – исследование, в ходе которого определяются физико-химические характеристики мочи и изучается ее осадок. Для анализа необходимо собрать среднюю порцию утренней мочи. Мочу следует доставить в лабораторию в течение 1-2 часов.
При миеломной болезни в моче могут быть обнаружены:
- повышение относительной плотности
- наличие эритроцитов
- повышенное содержание белка (протеинурия)
- присутствие цилиндров
- белок Бенс-Джонса – свыше 12 г/сут
Эти изменения указывают на поражение почек парапротеинами и нарушение белкового обмена.
-
Рентгенография костей – метод рентгенологического исследования для выявления поражений костей и подтверждения диагноза «миеломная болезнь». Проводятся снимки с передней и боковой проекции.
Изменения на рентгеновских снимках могут включать:
- признаки остеопороза
- «дырявый череп» – очаги разрушения в черепе
- отверстия в плечевых костях
- «изъеденные молью» ребра и лопатки
- сжатые позвонки
При рентгенографии запрещено использование контрастных веществ, так как йод может повредить почки.
-
Спиральная компьютерная томография (СКТ) – исследование, основанное на серии рентгеновских снимков под разными углами. Компьютер создает послойные «срезы» тела.
СКТ позволяет выявить:
- очаги разрушения костной ткани
- опухоли мягких тканей
- деформацию костей и позвонков
- ущемление спинного мозга
Это исследование помогает оценить распространенность миеломной болезни.
Лечение миеломной болезни
Для борьбы с миеломной болезнью используются следующие методы:
- химиотерапия – воздействие токсическими веществами на миеломные клетки
- трансплантация костного мозга или стволовых клеток
- лучевая терапия – лечение плазмоцитом с помощью ионизирующего излучения
- хирургическое вмешательство – удаление пораженной кости при наличии единичных плазмоцитом
Лечение миеломной болезни химиотерапией
Химиотерапия — основной метод лечения плазмоцитом.
Монохимиотерапия использует одно химиотерапевтическое средство.
| Препараты | Механизм действия | Способ применения | |
| Мелфалан | Эффективность около 50%. | Проникает в ДНК миеломных клеток, вызывает перекрестное связывание цепочек ДНК, останавливая размножение. | 0,15–0,2 мг на кг массы тела в течение 4 дней. Интервал между курсами — 4 недели. Можно принимать внутрь или вводить внутривенно. |
| Циклофосфамид (циклофосфан) | Эффективность при монотерапии — 50%. | Встраивается в ДНК злокачественных клеток, нарушая деление и вызывая их гибель. | Внутрь по 50–200 мг в течение 2-3 недель. Внутримышечно по 200–400 мг, 2-3 инъекции в неделю. Внутривенно по 600 мг на 1 кв. м, одна инъекция каждые 2 недели, всего 3 дозы. |
| Леналидомид | Эффективен у 60% пациентов, увеличивает выживаемость до 42 месяцев. | Укрепляет иммунитет против злокачественных клеток, активируя Т-киллеры и препятствуя образованию новых капилляров для опухолей. | Капсулу 25 мг следует проглотить целиком, запивая водой, ежедневно после еды. Курс 3 недели, затем 7-дневный перерыв. Дозу корректируют: 25, 15, 10, 5 мг. Принимается с дексаметазоном (по 40 мг 1 раз в день). |
Назначать химиотерапевтические препараты могут только опытные врачи-химиотерапевты. В процессе лечения необходимо постоянное наблюдение за состоянием пациента и анализами крови.
Полихимиотерапия — лечение миеломной болезни с использованием комбинации противоопухолевых средств.
Наиболее эффективные схемы полихимиотерапии — VAD и VBMCP. В течение 6 месяцев после диагноза проводят 3 курса полихимиотерапии.
Схема VAD
| Препараты | Механизм действия | Способ применения |
| Винкристин | Блокирует белок, необходимый для формирования микротрубочек миеломных клеток, останавливая их деление. | 0,4 мг/день в дни 1-4. Вводится внутривенно непрерывно в течение суток. |
| Адриамицин (доксорубицин) | Подавляет рост клеток, образуя свободные радикалы, которые угнетают синтез нуклеиновых кислот. | Вводится внутривенно по 9 мг/м² в день. Курс 1-4 дня в виде постоянной капельницы. |
| Дексаметазон | Предотвращает побочные эффекты химиотерапии. | Принимается внутрь или вводится внутривенно по 40 мг/день в дни 1-4, 9-12, 17-20. |
Схема VBMCP
| Препараты | Механизм действия | Способ применения |
| Кармустин | Угнетает обменные процессы в клетках, нарушая их энергообеспечение и деление. | Вводится внутривенно капельно в первый день лечения. Дозировка 100-200 мг/м². Следующая доза через 6 недель (по анализу крови). |
| Винкристин | Блокирует митотическое деление клеток. | Вводится внутривенно капельно по 1,4 мг/м² в первый день лечения. |
| Циклофосфамид | Оказывает токсическое воздействие на злокачественные клетки, нарушая целостность ДНК. | Назначается индивидуально, примерно 400 мг/м² внутривенно в 1-й день лечения. |
| Мелфалан | Останавливает синтез белка, необходимого для размножения миеломных клеток, разрушая их ДНК. | Применяется внутрь по 8 мг/м² в дни 1-7. |
| Преднизолон | Снижают побочные эффекты химиопрепаратов и предотвращают гиперкальцемию. | Принимается внутрь по 40 мг/м² в дни 1-7. |
После достижения ремиссии назначают интерферон альфа трижды в неделю по 3 млн ЕД для поддержания организма.
Химиотерапия может угнетать кроветворение, иногда требуется трансфузия эритроцитной, лейкоцитной или тромбоцитной массы.
Эффективность полихимиотерапии при миеломной болезни: у 41% пациентов достигается полная ремиссия, у 50% — частичная.
К сожалению, у многих пациентов, даже после успешного лечения, могут возникать рецидивы. Это связано с тем, что опухоль состоит из различных клеток: некоторые погибают во время химиотерапии, другие остаются и могут привести к новой опухоли. Обострение миеломной болезни лечится более активными препаратами.
Устранение симптомов миеломной болезни
-
Обезболивание
Обезболивание при миеломной болезни осуществляется по трехступенчатой схеме:
I ступень – для устранения слабой боли применяются нестероидные противовоспалительные средства (спазган, седалгин, индометацин, ибупрофен).
Препарат Механизм действия Способ применения Спазган Обладает обезболивающим, спазмолитическим и жаропонижающим эффектами. Блокирует окончания парасимпатических нервов, что способствует снятию спазмов и боли. Рекомендуется при болях в костях и внутренних органах. По 1 таблетке дважды в день, независимо от еды. Седалгин Обезболивающее с умеренной силой и успокаивающим эффектом. Подходит при сдавливании нервного корешка и болях вдоль спинномозгового нерва. По 1-2 таблетки 2-3 раза в день. Индометацин Препарат, который блокирует синтез простагландинов, отвечающих за возникновение боли. Один из наиболее мощных нестероидных анальгетиков. Принимается внутрь по 25 мг 2-3 раза в день после еды. Дозу можно увеличить до 150 мг в сутки при необходимости. Ибупрофен Замедляет синтез простагландинов и фермента циклооксигеназы, что уменьшает воспаление и боль. Эффективен при болях в костях и суставах. В таблетках по 0,2 г 3-4 раза в день. Рекомендуется принимать после еды для предотвращения раздражения слизистой желудка. II ступень – слабые опиоиды, также известные как наркотические анальгетики (кодеин, трамадол, дигидрокодеин, просидол). Их применяют для усиления обезболивающего эффекта в сочетании с нестероидными противовоспалительными средствами (парацетамол, диклофенак, кеторолак) при увеличении болевого синдрома.
Препарат Механизм действия Способ применения Кодеин Обладает болеутоляющим эффектом. Выделяемый из морфина, связывается с опиоидными рецепторами центральной нервной системы и блокирует передачу болевых сигналов. По 0,015 г 4 раза в день. Максимальная суточная доза – 0,06-0,09 г. Трамадол По 0,05 – 0,1 г 3-4 раза в день. Суточная доза не должна превышать 0,4 г. Дигидрокодеин По 0,06 – 0,12 г. Действие препарата длится до 12 часов, принимается 2-3 раза в день. Просидол Активирует обезболивающую систему на различных уровнях ЦНС, изменяя восприятие боли на эмоциональном уровне. Таблетки для рассасывания под языком по 0,01–0,02 г. Максимальная доза – 0,05–0,25 г в сутки. Внимание! Длительное применение может привести к привыканию и наркотической зависимости.
III ступень – опиоиды сильного действия (морфин, омнопон, бупренорфин, налоксон, дюрагезик) предпочтительны для лечения выраженной боли.
Препарат Механизм действия Способ применения Морфин Эффективно подавляет сильную боль, блокируя передачу болевых сигналов через нервные рецепторы. Обладает успокаивающим эффектом. По 0,01 г 4-5 раз в сутки. Омнопон Связывается с опиоидными рецепторами нервной системы, уменьшая чувствительность к боли. По 0,02–0,04 г 3-4 раза в день. Суточная доза не должна превышать 0,12 г. Бупренорфин По 0,2-0,4 мг. Эффективен в меньших дозах, чем морфин. Суточная доза не должна превышать 1,2-1,6 мг. Налоксон Вытесняет вещества, связывающиеся с болевыми рецепторами, блокируя их действие. Принимается по 0,4 мг не более 2 раз в день. Обязательно соблюдайте назначенные дозировки и рекомендации врача, чтобы минимизировать риск побочных эффектов и зависимости.
Процедуры для обезболивания при миеломной болезни
- Магнитотурботрон. Лечение с использованием магнитного поля низкой частоты оказывает положительное воздействие на организм:
- обладает противовоспалительным и обезболивающим эффектом
- замедляет митотическое деление злокачественных миеломных клеток
- усиливает иммунитет и активирует естественную противоопухолевую защиту
- снижает побочные эффекты химиотерапии.
Продолжительность процедуры – 10-15 минут. Курс – 10 сеансов. Рекомендуется повторять лечение дважды в год.
- Электросон. Воздействие на мозг импульсными токами низкой или звуковой частоты (1-130 Гц) вызывает:
- дремоту и сонливость
- уменьшение чувствительности к боли
- успокаивающее действие
Длительность процедуры – 30-90 минут. Курс лечения – 10-15 сеансов.
- Магнитотурботрон. Лечение с использованием магнитного поля низкой частоты оказывает положительное воздействие на организм:
-
Нарушение обмена кальция
Для нормализации состава крови необходимо употреблять 3-4 литра жидкости в день. Излишки кальция выводятся из организма с мочой, ее объем должен составлять 3-4 литра в сутки. Дважды в день контролируют уровень электролитов, чтобы поддерживать нормальные значения ионов калия и магния.
Препарат Механизм действия Способ применения Ибандронат натрия (Ибандроновая кислота) Подавляет разрушение костной ткани, снижает уровень кальция в крови. Предотвращает метастазы в кости. Назначается короткими курсами. Вводится внутривенно по 2-4 мг в сутки. Кальцитонин Регулирует обмен кальция в костной ткани, подавляет разрушение костей и способствует выведению кальция с мочой. Вводится подкожно или внутримышечно 6–12 ч по 4–8 МЕ/кг. Курс – 2-4 недели, затем дозу уменьшают и продолжают лечение еще 6 недель. Преднизолон Пульс-терапия высокими дозами для подавления воспалительных реакций. Замедляет активность В-лимфоцитов и миеломных клеток. 40 мг/м² принимают внутрь. Курс – 5-7 дней. Витамин D (эргокальциферол) Для профилактики остеопороза и разрушения костей. 300-500 ME в сутки в течение 45 дней. Андрогены: метандростенолон Нормализует обмен белков и укрепляет костную ткань в сочетании с витамином D. Принимают внутрь по 0,005-0,01 г в день перед едой. Курс – до 6 недель. -
Лечение почечной недостаточности при миеломной болезни
Повреждение значительного количества нефронов приводит к нарушению функции почек. Лечение почечной недостаточности направлено на борьбу с основным заболеванием. Цель – снизить количество миеломных клеток и их парапротеинов, которые накапливаются в почках. Также назначаются препараты для поддержки функции почек и средства для выведения токсинов.
Препарат Механизм действия Способ применения Хофитол Увеличивает выделение мочевины с мочой, способствует очищению крови. 5-10 мл вводят внутривенно или внутримышечно. Курс – 12 инъекций. Ретаболил Анаболический препарат, назначаемый для снижения уровня азота в крови. Азот из мочевины используется для синтеза белка в организме. Внутримышечно по 1 мл 1 раз в неделю. Курс – 2-3 недели. Натрия цитрат Применяется для коррекции кислотно-щелочного баланса и снижения кислотности крови. Одновременно уменьшает уровень кальция в крови. Принимается в таблетках по 1,5-2 г 3 раза в день после еды. Суточная доза не должна превышать 4-8 г. Празозин Периферический вазодилататор, который снижает артериальное давление, увеличивает почечный кровоток и улучшает клубочковую фильтрацию. Первую дозу принимают на ночь, лежа в постели. Возможны резкие колебания давления. В дальнейшем по 0,5-1 мг 2-3 раза в день. Каптоприл Ингибитор АПФ, который снижает сосудистое сопротивление и расширяет сосуды. Нормализует кровообращение в почках и способствует их нормальной работе. По 0,25-0,5 мг/кг 2 раза в день натощак. Можно под язык. Клубочковые диуретики (мочегонные) не рекомендуются при лечении миеломной болезни. Рекомендуется пить около 3 литров жидкости в день. Объем выделяемой мочи должен составлять 2-2,5 литра.
При отсутствии отеков нет необходимости ограничивать потребление соли, так как это может привести к нарушению электролитного баланса (слабость, потеря аппетита, обезвоживание).Рекомендуется диета с низким содержанием белка – до 40-60 г в сутки. Ограничивается потребление мяса, рыбы и яиц.
При высоком уровне мочевины в крови показан гемодиализ – очищение крови с помощью аппарата «искусственная почка».
Прогноз при миеломной болезни?
Выздоровление от миеломной болезни встречается редко. Избавиться от опухоли можно с помощью трех методов:
- Пересадка костного мозга
- Удаление пораженной кости
- Трансплантация гемопоэтических стволовых клеток с химиотерапией мелфаланом, что связано с высокой токсичностью и риском летального исхода (5-10%).
Длительная ремиссия возможна при следующих условиях:
- ранняя диагностика
- отсутствие серьезных сопутствующих заболеваний
- высокая чувствительность к цитостатической терапии
- хорошая переносимость лечения без выраженных побочных эффектов
Врачи разрабатывают индивидуальные схемы лечения для контроля заболевания. Комплексная химиотерапия и стероидные гормоны могут обеспечить ремиссию на 2-4 года, в некоторых случаях пациенты живут до 10 лет.
Среди пожилых людей химиотерапия в низких дозах с дексаметазоном обеспечивает 90% выживаемости на протяжении двух лет. Без лечения продолжительность жизни таких пациентов не превышает двух лет.
Вопрос-ответ
Чем отличается плазмоцитома от миеломы?
Плазмоцитома характеризуется клональной пролиферацией плазматических клеток, которые по морфологическим признакам идентичны клеткам при миеломной болезни, но в отличие от последней опухоль локализована либо в костной ткани (солитарная плазмоцитома кости), либо имеет внекостное расположение (внекостная плазмоцитома).
Каковы первые симптомы миеломной болезни?
Первые клинические проявления миеломной болезни — частые инфекции, астения, снижение работоспособности часто связаны именно с проявлениями недостаточной иммунной защиты. Множественная миелома занимает 2 место в рейтинге распространенности опухолей кроветворной системы.
Как лечится плазмоцитома?
Поскольку плазмоцитомы проявляют высокую чувствительность к радиоактивному облучению, основным методом лечения считается лучевая терапия. Химиотерапию с трансплантацией ауто-гемопоэтических стволовых клеток (ауто-ТГСК) применяют, как правило, у больных моложе 65 лет и без тяжелых сопутствующих заболеваний.
Сколько живут с плазмоцитомой?
Средний срок выживаемости пациентов с плазмоцитомой составляет 5 лет.
Советы
СОВЕТ №1
Регулярно проходите медицинские обследования. Раннее выявление миеломной болезни может значительно повысить шансы на успешное лечение. Обратите внимание на любые необычные симптомы, такие как постоянная усталость, боли в костях или частые инфекции, и не откладывайте визит к врачу.
СОВЕТ №2
Обсуждайте свои симптомы и историю болезни с врачом. Чем больше информации вы предоставите, тем легче будет врачу поставить правильный диагноз и назначить соответствующее лечение. Не стесняйтесь задавать вопросы и уточнять непонятные моменты.
СОВЕТ №3
Изучите доступные варианты лечения. Миеломная болезнь может требовать комплексного подхода, включая химиотерапию, иммунотерапию и трансплантацию стволовых клеток. Ознакомьтесь с различными методами и обсудите их с вашим лечащим врачом, чтобы выбрать наилучший план лечения.
СОВЕТ №4
Поддерживайте здоровый образ жизни. Правильное питание, регулярные физические нагрузки и управление стрессом могут помочь укрепить иммунную систему и улучшить общее состояние здоровья. Обсудите с врачом, какие изменения в образе жизни будут наиболее полезны для вас.